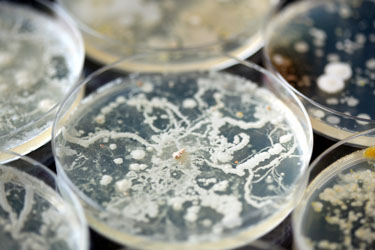
hsah-antibiotic-resistant-bacteria

-
Veterinarian Tips: Barn Safety
Sep 22, 2017Clients spend a lot of time in the barn with their animals. Give them these tips to help them spot potential problems and keep their barn safe! -
Veterinarian Tips: Mastitis Prevention and Treatment
Sep 18, 2017Money is lost when a cow develops mastitis. Pass this information on prevention and treatment on to your clients. -
Veterinarian Tips: Farm Biosecurity
Sep 15, 2017Here’s good advice on implementing a biosecurity plan to pass on to your farm clients. -
Protecting Against Antibiotic-Resistant Bacteria
Sep 13, 2017Antibiotic-resistant bacteria, developed by improper use in livestock, are affecting human health. Veterinarians are now in the front line of protecting against antibiotic-resistant bacteria. -
Veterinarian Tips: Hand-Raising Dairy Calves
Aug 31, 2017Raising healthy calves requires an investment of time and money, these tips will help to do it right!
Need Regulatory Assistance
If you need help with regulatory or licensing issues, we're happy to help. We have a wide variety of resources to help you when issues arise.

Careers
Are you looking for a place to let your talents shine? At Covetrus, we help our practitioner customers better serve their patients and take pride in providing the best customer experience possible. Search our open positions to see our available opportunities.
Newsletter
Stay current with what’s going on with Covetrus, subscribe to receive our newsletter and email communications. Subscribers will receive the latest information in practice management, sales and marketing, animal health, and more.